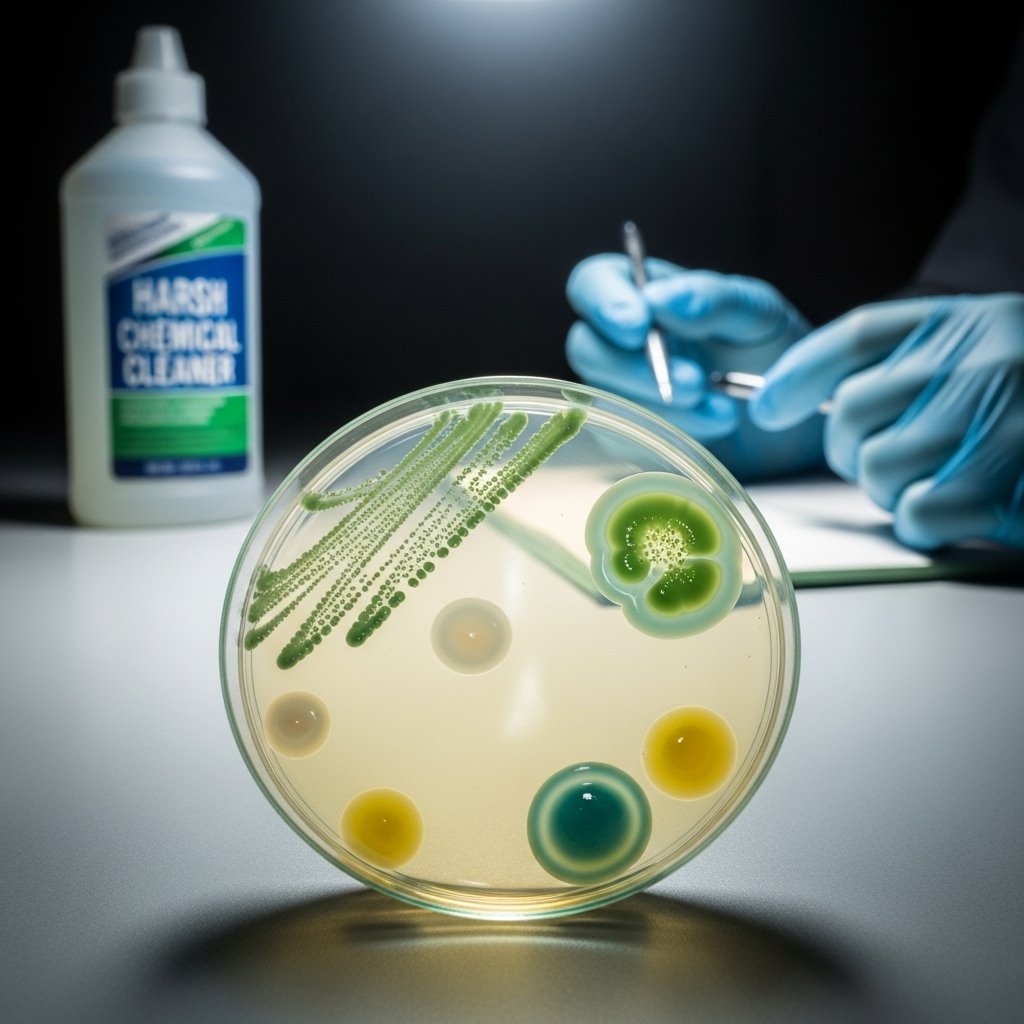

Gross! Stop Your Dog From Drinking Toilet Water Forever With These Hacks

As a pet owner, you’ve likely encountered a range of perplexing canine behaviors, but few are as universally unsettling as finding your beloved companion happily lapping water from the toilet bowl. While it may seem like a quirky, harmless habit, this common practice is more than just ‘gross’—it poses significant health risks to your dog. The toilet is not the pristine, personal water fountain your dog seems to think it is. It can be a reservoir for harmful bacteria and toxic cleaning chemicals.
This guide is designed to provide a definitive, expert-led approach to understanding and permanently resolving this issue. We will delve into the canine psychology behind this behavior, outline the serious health implications, and provide a multi-layered strategy for putting a stop to it. By combining simple management techniques, environmental enrichment, and positive reinforcement training, you can protect your dog’s health and restore sanitation in your home. Let’s begin the process of making the toilet bowl off-limits, forever.
Understanding the Allure: Why Dogs Are Drawn to the Toilet Bowl

Before we can correct the behavior, we must understand its origins from a canine perspective. A dog’s attraction to the toilet is not a sign of defiance; it’s rooted in instinct and sensory appeal. To your dog, the toilet bowl offers several advantages over a standard water dish.
Key Factors of Attraction:
- Cool and Fresh Water: The porcelain of the toilet bowl acts as a natural insulator, keeping the water cooler than water that has been sitting in a bowl for hours. Furthermore, each flush aerates the water, replenishing oxygen and enhancing its ‘fresh’ taste to a dog’s sensitive palate.
- Constant Availability: Unlike a water bowl that can run dry, the toilet is a perpetually refilling source. If a dog is particularly thirsty or their primary bowl is empty, the toilet presents a reliable alternative.
- Ergonomic Design: For many medium to large dog breeds, the height of a standard toilet bowl is more comfortable to drink from than a bowl on the floor, reducing neck strain.
- Sensory Stimulation: The swirling water and gurgling sounds of a flushing toilet can be intriguing to a curious dog, turning it into a source of entertainment as well as hydration.
In some cases, this behavior can also be a symptom of an underlying issue. A sudden increase in water-seeking behavior, known as polydipsia, may signal a medical condition. Understanding these root causes is the first critical step in developing an effective strategy to redirect your dog to a safer, healthier water source.
Beyond the ‘Ick’ Factor: The Real Dangers Lurking in Toilet Water
While the thought of your dog drinking from the toilet is unpleasant, the aesthetic concerns are minor compared to the genuine health hazards involved. The toilet bowl environment can expose your dog to a variety of contaminants that can lead to serious illness.
Primary Health Risks:
- Bacterial Contamination: Toilets, even those that appear clean, can harbor bacteria from human waste. Pathogens such as E. coli, Giardia, and Salmonella can be present and may cause severe gastrointestinal distress in your dog, leading to symptoms like vomiting, diarrhea, and dehydration.
- Chemical Poisoning: This is perhaps the most acute danger. The residue from chemical toilet bowl cleaners, bleach, and in-tank deodorizing tablets can be highly toxic. Ingesting these substances can cause chemical burns to the mouth and esophagus, stomach ulcers, and potentially fatal systemic poisoning. The risk is especially high immediately after a cleaning.
- Parasites: Though less common in modern, sanitary households, there remains a small risk of transmitting certain intestinal parasites if a household member is infected.
- Physical Injury: Beyond contaminants, the toilet itself can be a hazard. A heavy lid could slam shut on a dog’s head or neck, causing serious injury. Smaller dogs or puppies could even be at risk of falling in and drowning.
Expert Tip: Never use in-tank ‘drop-in’ cleaning tablets if you have a pet in the house. These products continually release chemicals into the water, making every flush potentially toxic for a curious dog.
Recognizing these dangers transforms the issue from a simple nuisance into a critical pet safety priority. Protecting your dog means ensuring they are never exposed to these preventable risks.
Strategy 1: Proactive Management and Prevention

The most immediate and effective way to stop your dog from drinking from the toilet is through simple, consistent management. This strategy focuses on physically preventing access, requiring no training but demanding diligence from everyone in the household.
Immediate Actions to Implement:
- Keep the Lid Down: This is the simplest and most crucial step. Make it a non-negotiable household rule for every family member and guest to close the toilet lid after every use. For many dogs, this single barrier is enough to deter them.
- Close the Bathroom Door: If keeping the lid down proves difficult to enforce, the next best option is to keep the bathroom door securely closed at all times. This removes the temptation entirely.
- Install a Lid Lock: For particularly clever or persistent dogs who might learn to nudge the lid open, a toilet lid lock can be an invaluable tool. These are often marketed as child-proofing devices but are perfectly effective for pets.
Management is your first line of defense. It instantly makes the behavior impossible and creates a safe environment while you work on the longer-term solutions of enrichment and training. Consistency is paramount; a single lapse can reinforce the old habit, so establishing firm household rules is essential for success.
Strategy 2: Upgrading Your Dog’s Water Station

To successfully redirect your dog away from the toilet, you must provide an alternative that is even more appealing. The goal is to make their designated water bowl the most attractive hydration source in the house. This involves upgrading their entire drinking experience.
How to Create an Irresistible Water Station:
- Invest in a Pet Water Fountain: These devices are game-changers. They circulate and filter water, keeping it cool, aerated, and fresh-tasting—mimicking the very qualities that make the toilet so alluring. The gentle sound of moving water also attracts many dogs.
- Increase the Number of Bowls: Place multiple, fresh water bowls in different locations throughout your home, especially in high-traffic areas. This ensures your dog never has to search for water and a safe option is always conveniently nearby.
- Prioritize Cleanliness: A dog’s sense of smell is powerful. A slimy, dirty water bowl is highly unappealing. Wash your dog’s water bowls with soap and water daily to prevent the buildup of biofilm, a slimy bacterial layer that not only tastes bad but can be harmful.
- Choose the Right Material: The material of the bowl matters. Stainless steel and ceramic are excellent choices as they are non-porous, easy to clean, and help keep water cool. Plastic bowls can scratch easily, harboring bacteria and retaining odors.
By making your dog’s official water station the best option available, you address the root cause of their toilet-seeking behavior. You are not just taking away a ‘bad’ option; you are replacing it with a far superior one.
| Water Source Type | Key Benefits | Considerations |
|---|---|---|
| Stainless Steel Bowl | Durable, non-porous, easy to sanitize, keeps water cool. | Water can become stagnant if not changed frequently. |
| Ceramic Bowl | Heavy (prevents tipping), keeps water cool, aesthetically pleasing. | Can chip or crack, must be glazed and lead-free. |
| Pet Water Fountain | Provides constant filtered, cool, aerated water. Encourages drinking. | Requires electricity, filter changes, and regular deep cleaning. |
| Plastic Bowl | Inexpensive and lightweight. | Scratches easily, can harbor bacteria and cause ‘plastic acne’. Generally not recommended. |
Strategy 3: Positive Reinforcement Training to Solidify New Habits

While management prevents the behavior and a better water station provides an alternative, training solidifies the correct choice in your dog’s mind. Positive reinforcement is the key to teaching your dog that drinking from their own bowl is a highly rewarding activity.
Training Techniques:
- Reward the Right Choice: Whenever you see your dog voluntarily drink from their designated water bowl or fountain, offer immediate praise. Use an enthusiastic tone—’Good drink!’—and reward them with a small, high-value treat right after they finish. This creates a powerful positive association with their water bowl.
- Teach the ‘Leave It’ Command: ‘Leave It’ is an essential command for all dog owners. Practice this in a controlled environment with low-value items and gradually work up to more tempting objects. Once reliable, you can use it if you catch your dog heading toward the bathroom. A firm ‘Leave It!’ followed by redirecting them to their own bowl and rewarding them there is a highly effective sequence.
- Interrupt and Redirect, Don’t Punish: If you find your dog in the act, avoid yelling or punishing them. This can create fear and anxiety around you and may simply teach them to be sneakier. Instead, use a calm but firm interrupter, such as a clap or a sharp ‘Ah-ah!’. As soon as you have their attention, call them enthusiastically to their water bowl. When they investigate or drink from it, praise them lavishly.
Training requires patience and consistency from all family members. Over time, your dog will learn that the toilet is off-limits and that their own water station is a source of delicious water and positive attention from you. This final layer of training transforms a managed behavior into a reliable, lifelong habit.
When Excessive Thirst is a Medical Concern

In most cases, drinking from the toilet is a behavioral issue. However, it’s critical to recognize when it might be a symptom of an underlying health problem. A sudden and insatiable need to drink water, a condition known as polydipsia, is a significant red flag that warrants an immediate veterinary consultation.
Watch for These Accompanying Symptoms:
- Sudden Onset: The behavior appears suddenly in an adult or senior dog that has never done it before.
- Obsessive Behavior: Your dog seems frantic to get to water sources, not just the toilet but also puddles, sinks, or shower floors.
- Increased Urination (Polyuria): Excessive drinking is almost always paired with excessive urination. You may notice more frequent requests to go outside or an increase in household accidents.
- Other Health Changes: Polydipsia is often accompanied by other signs of illness, such as lethargy, changes in appetite, weight loss, or a dull coat.
Several serious medical conditions can cause excessive thirst, including:
- Kidney Disease
- Diabetes Mellitus
- Cushing’s Disease
- Liver Disease
- Pyometra (in unspayed female dogs)
If your dog’s toilet-drinking habit is new, compulsive, or coupled with any of the symptoms above, do not dismiss it as a behavioral quirk. Schedule an appointment with your veterinarian immediately for a thorough examination and diagnostic testing.
Conclusion
Putting an end to your dog’s toilet-drinking habit is an achievable goal that significantly benefits their health and your peace of mind. By implementing a robust, three-tiered strategy, you can effectively resolve this issue for good. Begin with diligent management by keeping lids down and doors closed to immediately remove the opportunity. Simultaneously, upgrade your dog’s hydration station with fresh water, clean bowls, or a pet fountain to provide a more appealing alternative. Finally, solidify these new, positive habits with consistent training, using positive reinforcement to reward your dog for making the right choice.
Remember to remain vigilant for any signs of excessive thirst that could indicate a medical problem and consult your veterinarian if you have any concerns. With consistency and a proactive approach, the toilet will soon be just a toilet again, and your dog will be happily and safely hydrated from their own designated, superior water source.






